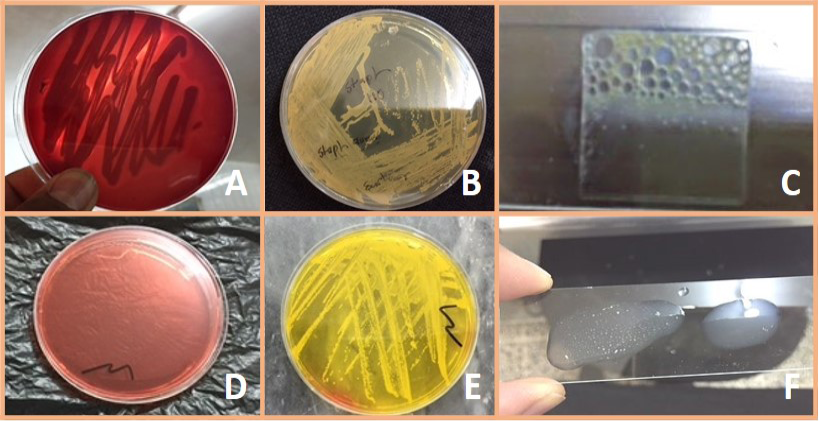
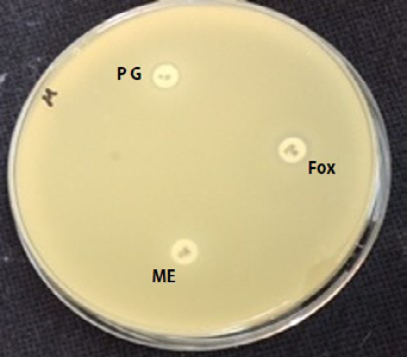
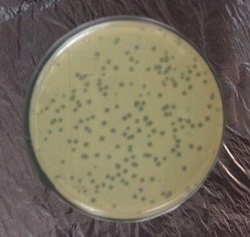
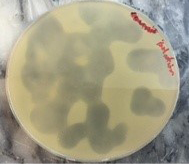

Advances in Animal and Veterinary Sciences
Research Article
Adv. Anim. Vet. Sci. 4(10): 550-562
Figure 1
A) Staph aureus on blood agar (β – Hemolysis); B) Staph. aureus on Staph 110 agar (Creamy to yellow or orange); C) Positive catalase test; D) Mannitol salt agar without S. aureus culture; E) Fermentation of mannitol salt agar by S. aureus. (Formation of yellow color colony); F) Positive coagulase test
Figure 2
Antibiotic sensitivity of S. aureus showed MRSA
Figure 3
Plaques formed after 24 hrs incubation on MRSA culture
Figure 4
Spot lysis test after 24 hrs incubation
Figure 5
Minimum inhibitory concentration of bacteriophage against MRSA